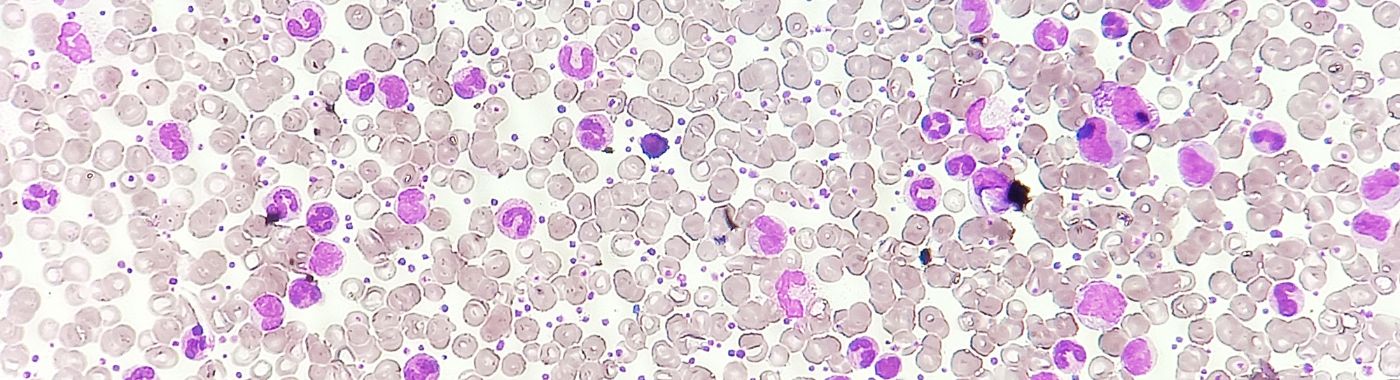
Chronic Myelogenous Leukemia - Early Signs, Risk Factors, Diagnosis, and Treatment Explained

Could not find what you are looking for?
Disease and condition
Detailed Insights into Causes, Risk Factors, Prevention, and Management
Disease and condition (2339)
Read More


Chronic Lymphocytic Leukemia (CLL) - Early Signs, Risk Factors, Diagnosis, and Treatment Explained
Read More

Chronic Myelogenous Leukemia - Early Signs, Risk Factors, Diagnosis, and Treatment Explained














 Best Hospital Near me Chennai
Best Hospital Near me Chennai

